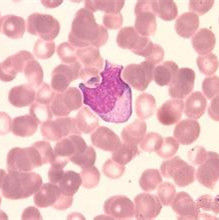
異形細胞 異形細胞

單獨地或成群地存在,有時形成異常組織。丹寧細胞、結晶細胞等均為異形細胞。狹義的異形細胞是指厚壁細胞的一種,是形狀、大小、增厚程度、紋孔形狀等為特徵的,許多情況是死細胞。在各種葉組織、維管束組織內廣泛存在。有呈規則的分枝在組織內擴展著的如(山茶Came- llia japonica)、昆欄樹(Trochodendron aralioides)、金松(Sciadopitys erticillata的葉):有壁內伴有碳酸鈣的沉積。作星狀分枝細胞間隙突出形成星狀異常組織或內毛(紅茹冬Rhizophora mucrona- ta、蓮Nelumbo nuifera、苹蓬草Nuphar japonic-um的葉柄)的,或幾乎沒有分枝而伸長的(菜豆Phaseolus vulgaris的種皮、蔥Allium fistylosum的鱗葉或莖表皮等)。此外,木瓜(Pseudocydonia si- nensis)、梨(Pyrus pyrifolia var.culta)、越桔(Vaccinium vitis-idaea var.minus)果肉中的石細胞也屬於異形細胞。
相關詞條
-
隨身帶著異形王后
《隨身帶著異形王后》 是龍青衫2009年所寫的玄幻小說,連載於起點中文網。 莫名其妙穿越到一個鬥氣橫行魔法高深的異世界,太倒霉了吧!主角沒有高明的武技、...
內容簡介 作品榮譽 作品目錄 -
異形水綿
異形水綿,一種植物,屬於雙星藻科水綿屬,全國各地皆有。
簡介 物種描述 國內分布 -
腫瘤[▪細胞產生的贅生物細胞群]
腫瘤(tumor)是機體在各種致癌因素作用下,局部組織的某一個細胞在基因水平上失去對其生長的正常調控,導致其克隆性異常增生而形成的新生物(neogrow...
簡介 腫瘤的一般形態與結構 腫瘤的命名和分類 腫瘤的異型性 腫瘤細胞的代謝特點 -
同源異形盒基因
控制果蠅長觸角的基因發生突變,果蠅的前肢就可能長到應該生觸角的部位上去。若控制胸部基因發生了突變,則胸部第3體節變成為長翅膀的第2體節,結果使本來應長2...
同源異形盒基因 內容 -
異形前傳:普羅米修斯
異形前傳:普羅米修斯由導演雷德利·斯科特所執導,影星勞米·拉佩斯,麥可·法斯賓德,蓋·皮爾斯,查理茲·塞隆等主演,影片於2012年6月8日上映。
電影劇情 演職員表 精彩對白 影片評價 影片製作 -
性細胞
遺傳學和細胞生物學名詞,也作生殖細胞或配子,是單倍體細胞,它由行有性生殖的生物在特定的器官通過減數分裂產生。兩性生殖細胞通過配子結合產生合子。您身體中的...
概述 分化 產生 形成條件 結合 -
異形胞
異形胞由絲狀藍藻等的細胞列中的普通的營養細胞在一定的條件下分化而成。
-
同源異形框
同源框基因是一種同源異形基因,在胚胎髮育過程中將空間特異性賦予身體前後軸不同部位的細胞,進而影響細胞分化。
簡介 相關條目